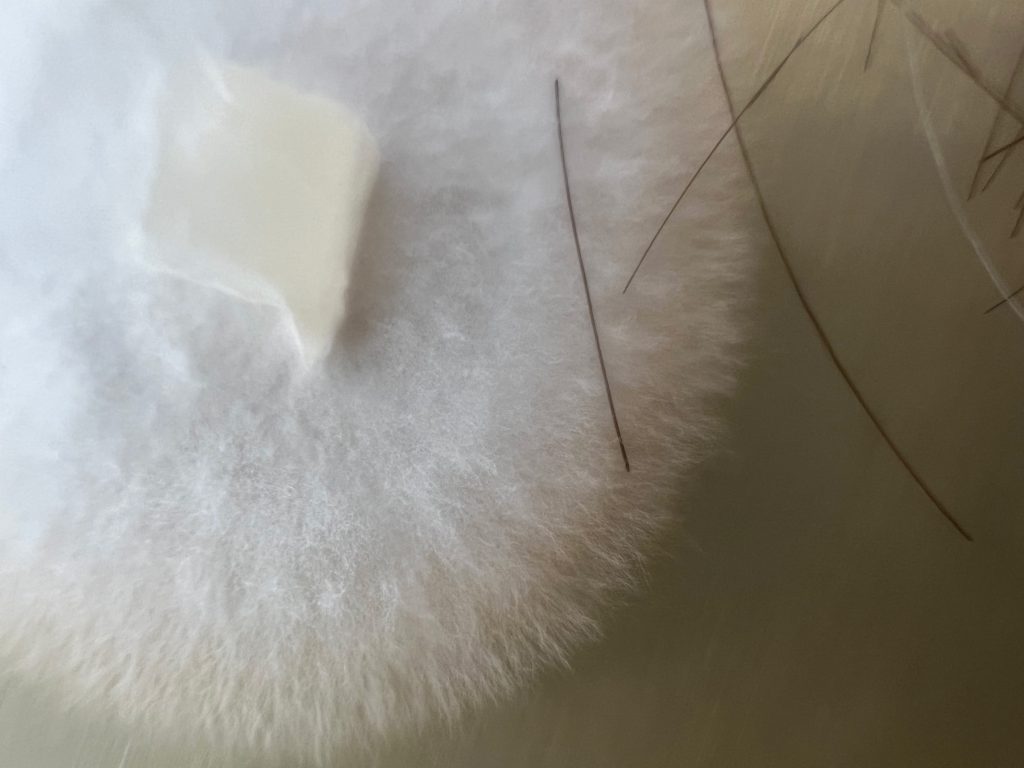

Solo exhibition @ Kunst () Klima project space – Stuttgart, April 19-May 17, 2024 / Public talk: May 17, 2024
Collaboration partners: Ganoderma applanatum (fungus), Christina Maria Pfeifer (artist), J. Philipp Benz (biotechnologist at TUM School of Life Sciences), Sabrina Klasen (laboratory assistance), Daimler E-Class combustion engine (KFZ Meisterbetrieb Schwabing), Maple tree trunk.

The exhibition is a sci-fi experiment and the fungus Ganoderma applanatum is the main agency. With reference to Stuttgart, the artist has brought the exhaust soot of a Daimler E-Class, her hair and wood from the forest in relation with the finest hyphae of the fungus. From this, the fungus has woven in the laboratory of J. Philipp Benz at TUM School of Life Sciences a new kind of microbiome that emerges as a multispecies from fungi, tree, car and human species.
The artist repeated the experiment in a performance with the participation of the visitors at the opening. Further Composts of Newborns will emerge during the exhibition period, then under the climatic conditions of the project space.